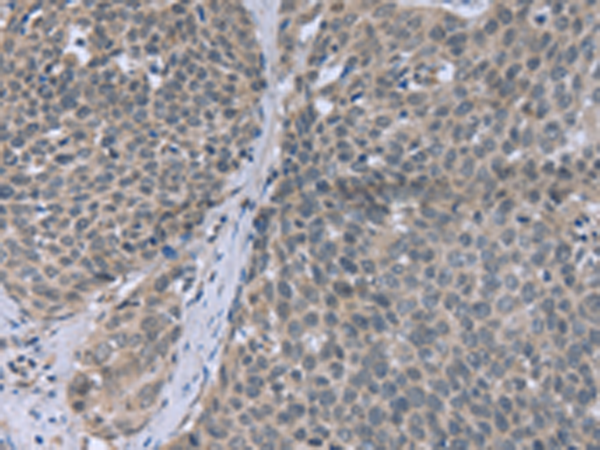

|
Background: |
The Fanconi anemia complementation group (FANC) currently includes FANCA, FANCB, FANCC, FANCD1 (also called BRCA2), FANCD2, FANCE, FANCF, FANCG, FANCI, FANCJ (also called BRIP1), FANCL, FANCM and FANCN (also called PALB2). The previously defined group FANCH is the same as FANCA. Fanconi anemia is a genetically heterogeneous recessive disorder characterized by cytogenetic instability, hypersensitivity to DNA crosslinking agents, increased chromosomal breakage, and defective DNA repair. The members of the Fanconi anemia complementation group do not share sequence similarity; they are related by their assembly into a common nuclear protein complex. This gene encodes the protein for complementation group G. |
|
Applications: |
ELISA, IHC |
|
Name of antibody: |
FANCG |
|
Immunogen: |
Fusion protein of human FANCG |
|
Full name: |
Fanconi anemia, complementation group G |
|
Synonyms: |
FAG; XRCC9 |
|
SwissProt: |
O15287 |
|
ELISA Recommended dilution: |
1000-2000 |
|
IHC positive control: |
Human cervical cancer and Human colon cancer |
|
IHC Recommend dilution: |
25-100 |
購物車
幫助
021-54845833/15800441009
